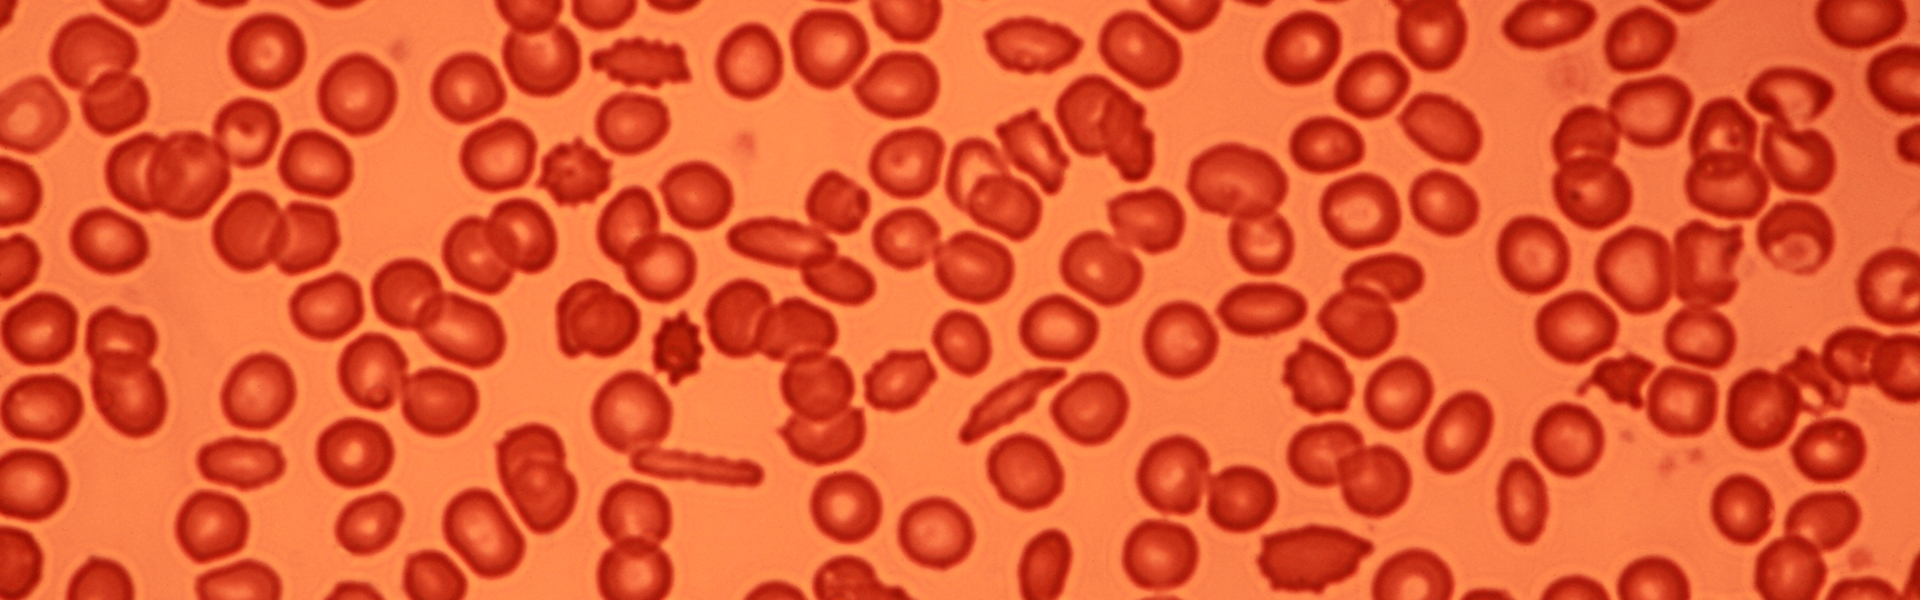
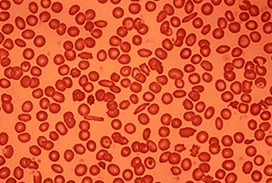

RELATED LINKS
Clinical Faculty AffairsCentre for Quality, Innovation and Safety
Department of Medicine
Schulich Medicine & Dentistry Research Office
Western Research
CONTACT US
Hematology
Schulich Medicine & Dentistry,
Western University
London, Ontario
800 Commissioners Rd E,
Rm. E6-211
t. 519.685.8479
f. 519.685.8294